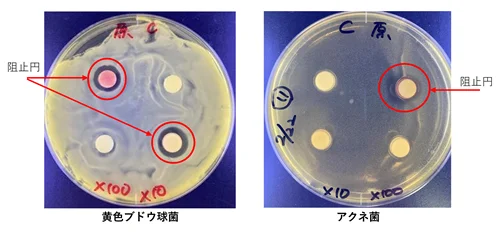

10月1日開始 新日本製薬が国産化粧品原料2種を法人販売
ベストカレンダー編集部
2025年9月18日 15:54
法人向け原料販売開始
開催日:10月1日

新日本製薬が国内研究で得た2種の化粧品原料を法人向けに販売開始
新日本製薬 株式会社は、長年の栽培研究と機能性評価の成果として得られた化粧品原料を、2025年10月1日より法人向けに販売開始します。リリースは2025年9月18日13時00分付で発表されました。
販売対象となる原料は、絶滅危惧IB類に指定されている薬用植物ムラサキの根から抽出した油溶性シコンエキス(販売原料名:油溶性シコンエキス Cen)と、日本で開発されたスペインカンゾウの独自品種から抽出したカンゾウフラボノイド(販売原料名:カンゾウフラボノイド SG P)の2種類です。以下に両原料の特徴、研究内容、販売概要、問い合わせ先、ならびに企業情報を整理して伝えます。

成分の特長と試験データ:シコンエキスの機能性
シコンエキスは、ムラサキの根である紫根(シコン)から抽出される成分で、古くから皮膚の治療用途に用いられてきました。新日本製薬は2006年から国内での栽培に取り組み、独自の栽培技術を確立したうえで抽出原料を開発しています。
同社の評価では、シコンエキスが以下のような機能性を示すことが実験的に確認されています。試験は細胞レベルでの評価が中心です。

コラーゲン産生のサポート
線維芽細胞を用いた評価で、シコニン類(シコニンおよびアセチルシコニン)を含む培地に置換後、3日間の培養で蛍光染色(Hoechst試薬)および蛍光強度測定(Ex=355nm、Em=460nm)を行い、線維芽細胞の増殖促進を確認しました。
具体的には、シコニン類が0.01~0.1μMの低濃度において線維芽細胞を増殖させる効果が観察され、これにより肌のハリや弾力を保つ効果が期待できると示されています。
育毛をサポートする作用および抗菌性
ヒト由来毛乳頭細胞を用いた実験では、シコンエキス(シコニン含有)を添加した培地で2日後に蛍光染色および蛍光強度測定を実施し、対照(サンプルを含まない培地を100とした場合)に比べて約10%の増殖が認められました。ビタミンCと比較しても増殖効果が高いと報告されています。
また、抗菌効果については黄色ブドウ球菌およびアクネ菌を用いたディスク拡散法相当の試験が行われ、シコンエキス含有フィルター周辺に菌の生育が見られない阻止円(菌が生育していない円状のエリア)が確認されました。これによりニキビ等の肌トラブル予防への可能性が示唆されています。
- 試験対象細胞:正常ヒト皮膚由来線維芽細胞(NB1RGB)、ヒト由来毛乳頭細胞
- 主要測定法:蛍光染色(Hoechst)、蛍光強度測定(Ex=355nm、Em=460nm)、阻止円観察
- 有効濃度域:シコニン類 0.01~0.1μMでの増殖効果確認

成分の特長と試験データ:カンゾウフラボノイドの機能性
カンゾウフラボノイドは、甘草(カンゾウ)の根から抽出したフラボノイド系成分で、同社は輸入に依存せず国内で安定的に生産するための栽培技術と品種開発を行ってきました。特にスペインカンゾウに着目し、日本で初めての新品種を開発しています。
研究結果として、カンゾウフラボノイドにはメラニン生成抑制の作用が示されており、シミ予防効果が期待されることが確認されています。評価はB16細胞を用いたメラニン量の測定で行われています。

B16細胞を用いたメラニン生成抑制試験
試験ではB16細胞を播種した翌日にカンゾウフラボノイド含有培地を添加し、2日後にメラニン量を測定しました。メラニン量は10%DMSO含有の1N NaOHで溶解後、吸光度490nmで測定し、Bradford法でタンパク質あたりのメラニン量を算出しています。
その結果、カンゾウフラボノイドは0.0005%までの濃度域でメラニン量の穏やかな減少傾向を示しました。これによりシミ予防の有用性が示唆されています。
- 試験対象細胞:B16細胞
- 主要測定法:メラニン量測定(吸光度490nm)、Bradford法による標準化
- 有効濃度域:0.0005%まででメラニン量の減少傾向を確認

栽培研究、品種登録、特許などの技術的背景
両原料に共通する特徴として、新日本製薬は原料の安定供給と品質確保を目的に、2006年以降の長期にわたる栽培研究を継続してきました。栽培法や品種選抜に関する知見をもとに、国内生産を可能にする技術を確立しています。
以下に主要な技術的事項と登録・特許情報を示します。
- ムラサキ(紫根)の栽培技術
- 2006年より国内栽培に取り組み、ムラサキの生存率向上と有効成分含有量増加を実現する独自の栽培方法を開発。特許第5885320号(登録日:2016年2月19日、発明の名称:ムラサキの栽培方法)として登録されています。
- 甘草(カンゾウ)の栽培技術
- 国内での安定確保を目指し、根を肥大化させるためのストロン抑制短筒栽培法(特許第5635714号、登録日:2014年10月24日)を開発しました。これにより国内栽培での安定生産が可能となっています。
- スペインカンゾウの品種登録
- スペインカンゾウ(Glycyrrhiza glabra)に着目して品種改良を行い、選抜・再現性確認を経て、新品種「新日本製薬GG01」を開発。植栽から1年半で日本薬局方のグリチルリチン酸含有基準(2.0%)を満たし、登録番号29026(登録品種の名称:新日本製薬GG01、属名:Glycyrrhiza glabra L.)として2022年3月に登録されました。
これらの技術的基盤により、同社は従来輸入に頼る原料供給構造に対して国産代替を提案しています。

販売概要、問い合わせ先、企業情報
販売は法人向けで、下記の製品仕様および販売開始日が発表されています。販売は新日本製薬のコーポレートサイト内「お問い合わせ」フォームを通じて受け付けられます。
販売原料名 | 規格・容量 |
---|---|
油溶性シコンエキス Cen | 800 g |
カンゾウフラボノイド SG P | 5 g(1 g×5袋) |
販売開始日:2025年10月1日(水)
問い合わせ先:新日本製薬 株式会社 コーポレートサイト内「お問い合わせ」フォーム(https://corporate.shinnihonseiyaku.co.jp/contact/)
プレスリリースに関する注記として、文中では生薬を漢字表記、植物名・原料名をカタカナ表記で統一していること、また本リリースは薬機法等の諸法規に基づくものではない旨が記されています。

新日本製薬の研究開発と会社概要
同社は「美と健康の『新しい』で、笑顔あふれる毎日をつくる。」というパーパスのもと、スマート“ライフ”サイエンスの方針で研究開発を進めています。コラーゲンやムラサキに関する特許、紫根や成分の浸透促進に関する特許などを取得しており、大学やパートナー企業と連携して新素材の研究を推進しています。
会社概要は以下の通りです。
- 会社名:新日本製薬 株式会社
- 所在地:福岡県福岡市中央区大手門1丁目4-7
- 代表者:代表取締役社長CEO 後藤 孝洋
- 設立:1992年3月
- 事業内容:化粧品、健康食品、医薬品の企画及び通信販売・卸販売
- URL:https://corporate.shinnihonseiyaku.co.jp/
- 研究開発サイト:https://corporate.shinnihonseiyaku.co.jp/rd/
以上が本リリースの主要内容です。以下に本文で触れた重要事項を表にまとめ、記事を締めます。
項目 | 内容 |
---|---|
リリース日 | 2025年9月18日 13:00 |
販売開始日 | 2025年10月1日(水) |
販売対象原料 | 油溶性シコンエキス Cen(ムラサキ由来)、カンゾウフラボノイド SG P(スペインカンゾウ由来・新品種) |
容量 | 油溶性シコンエキス Cen:800 g、カンゾウフラボノイド SG P:5 g(1 g×5袋) |
主な機能性 | シコンエキス:コラーゲン産生サポート、育毛サポート、抗菌作用。カンゾウフラボノイド:メラニン生成抑制(シミ予防) |
主要試験・結果 | 線維芽細胞増殖(シコニン類 0.01〜0.1μMで増殖)、毛乳頭細胞約10%増殖、抗菌試験で阻止円確認、B16細胞でメラニン量の減少傾向(0.0005%まで) |
特許・登録 | ムラサキ栽培法:特許第5885320号(登録日:2016/02/19)、カンゾウ栽培法:特許第5635714号(登録日:2014/10/24)、品種登録:登録番号29026(新日本製薬GG01、Glycyrrhiza glabra L.、登録 2022年3月) |
問い合わせ | https://corporate.shinnihonseiyaku.co.jp/contact/ |
備考 | 本文中は生薬を漢字、植物名・原料名をカタカナで表記。薬機法等に基づく表現ではない旨の注記あり。 |
本記事は新日本製薬が公表したプレスリリースの内容に基づいて、原料の特性、試験結果、栽培・品種開発、販売条件および企業情報を整理して伝えるものであり、法的効能や臨床評価を保証するものではありません。製品利用や開発を検討する事業者は、同社の指定する窓口を通じて詳細な諸条件や使用上の注意、試験データの原資料等を確認することが望まれます。